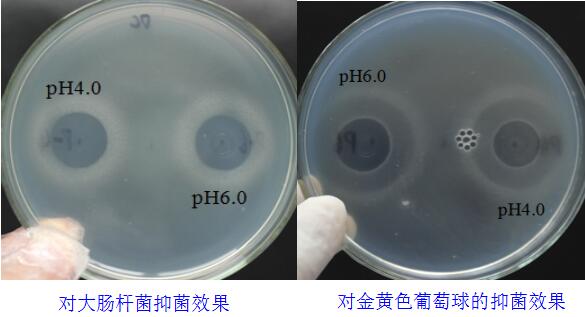
uploads/image/20240628/1719570940.jpg

抑菌、调肠、促生长
圣道生物(山东)集团有限公司
肠康T-20为圣道生物集团肠康系列产品,由集团技术专家与畜禽营养专家和预防兽医专家联合打造,针对精确选取特异型有益菌和益生元,科学配伍而成的抑制病原菌、修复肠道绒毛与黏膜损伤、控制肠道炎症、增强免疫力、减少应激损伤,肠道健康调控方案。
【产品组成】
丁酸梭菌、粪肠球菌、枯草芽孢杆菌(歼20)、酿酒酵母提取物、酿酒酵母培养物。
【产品原理】
三大益生菌高效抑制以产气荚膜梭菌为主的多种肠道致病菌的数量,维护畜禽肠道双歧杆菌、乳酸菌等有益菌的数量,改善肠道微生态平衡;同时三大益生菌从多方面修复肠道黏膜损伤,形成肠道屏障,维护肠道健康;三大益生菌还能在肠道中产生多种分解酶,促进畜禽对脂肪和蛋白质等营养物质的吸收利用。
酶解酵母多糖与三大益生菌均可直接激活增强畜禽机体T、B淋巴细胞的免疫功能,增强畜禽机体抗炎能力;酶解酵母多糖中β-1-3-D葡聚糖和甘露聚糖对于畜禽肠道中致病菌同样有着明显的抑制作用,与三大益生菌起到协同作用。

【产品特点】
Ø 运用现在微生物平衡技术、抑菌抗感染技术和肠道修复技术三大核心技术打造;
Ø 多种有效成分协同配伍维护畜禽肠道健康,提高畜禽生产性能;
Ø 多靶点强化效果针对肠道炎症。
【产品功能】
抑菌抗感染维护肠道稳态:肠康T-20对产气荚膜梭菌等特异性致病菌具有抑制作用,同时能够促进双歧杆菌、乳酸菌等有益菌的生长,改善肠道菌群,从而减少肠道感染和肠炎发生几率,是最有效非抗生素抑菌方案;
抗炎免疫提升:肠康T-20中多种有效成分可直接作用于T、B淋巴细胞,提高免疫球蛋白的含量,改善机体免疫系统功能状态,增强机体的抗炎抑菌能力。
肠道修复生成保护屏障:肠康T-20能够有效修复肠道黏膜损伤,促进肠道上皮组织细胞再生,并生成肠道保护屏障,抵御外来病菌病毒及霉菌毒素等的影响,维护畜禽肠道健康。
强化吸收促生长:肠康T-20在畜禽肠道中产生益生产物以及消化酶,促进畜禽机体分解吸收蛋白质和脂肪等营养物质,同时还能软化纤维,提高饲料利用率,促进畜禽生长发育。
【适用动物】猪专用
【使用方案】
常规用量:养殖全程添加,每公斤产品配料2吨;
加强用量:保证肠道健康添加,每公斤产品配料1吨;
治疗用量:对抗应激每公斤产品配料0.5吨。
